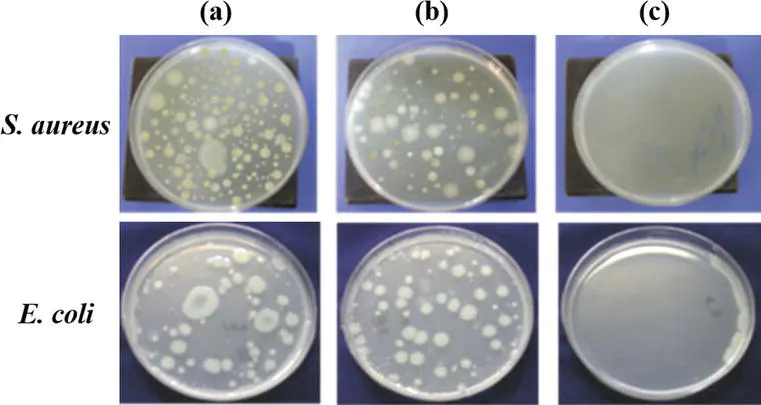

①230gという驚異的な軽量真空ボトル
②医療グレードのチタン製品をできるだけ手頃な値段で!
③チタンの持つ抗菌効果で飲み物を清潔に保つ

人工関節や航空機のエンジンなどに使われる金属チタンは軽いのに丈夫なだけでなく、
強力な抗菌作用を持つ特殊な金属です。
この金属を私たちが一番頻繁に使うドリンクのサーモボトルとカトラリー(別ページで行なっているクラウドファンディング)に利用しようと思い、このプロジェクト(プロジェクト名XXII)を立ち上げました。
プロジェクト名のXXIIはギリシャ数字で22、チタンの原子番号を示しています。

指数関数的に増える細菌
下の図は私たちの唾液からタンブラーの中に入ったバクテリアの増殖スピードを示しています。
対数グラフなので縦の1目盛りは10倍を意味しています。びっくりするような速度でタンブラーの中で
バクテリアが増殖していく様子が見えます。

https://www.britannica.com/science/bacteria/Growth-of-bacterial-populations より引用
酸化皮膜TIO2
チタンの表面は酸素と結合することで、薄い酸化チタン(IV)またはチタニアとしても知られるTiO 2(二酸化チタン)の膜を作ります。
この酸化チタンには強力な抗菌作用があり、以下のようにバクテリアの増殖をとことん食い止める力があります。
上記の図、(a)と(b)はステンレス、(c)は酸化チタンの抗菌性能を示しています。
このような抗菌力によって、チタン製のサーモボトルを利用すると中身が腐食する速度を3分の1以下にすることができます。
いかにチタンの抗菌能力が強いかがお分りいただけると思います。
XXIIサーモボトルの仕様
直径 66mm
高さ 210mm
容量 480ml
重量 230g
色 ダークブルー/メタルチタンの2色
材質 チタン
*デザインの詳細は変更される場合があります。
真空ボトルの保温力
- 保温効力(6時間/1時間):69℃以上/86℃以上
- 保冷効力(6時間):8℃以下

100℃のお湯を6時間入れておいても69℃以上を保つことができるのは独自技術の真空ボトルの能力です。また保冷能力も同様に優れた性能を示しています。
マグカップのような口あたり
カップの入り口は滑らかで口元に優しいタッチの仕上がりとなっております。



今回のお金の使い道
当社は現在一生懸命チタン製品を複数開発しておりますが、チタン素材は非常に硬く、高価な素材のため、
新規の商品開発には多額の費用がかかります。
本クラウドファンディングを通じて集められた資金は、現在または今後のチタン製品開発の研究資金に利用させていただきます。
リターンのご紹介
リターンは本商品XXII真空サーモボトル(ダークブルーまたはメタルチタン)となります。XXII真空サーモボトルを複数分ご支援いただけますと、リターンがお得になるように設定しましたので、是非2つ、3つまとめてご支援いただけますと嬉しいです。
お得な早割を少しの数ではありますが、実施します。

私たちAML社は日本人が中心となった多文化企業です
当社は香港に本社を構えるオンライン型の多文化多国籍企業で日本人、イタリア人、香港人、中国人で構成されています。それぞれの国ごとに強み弱みがあります。
当社ではその強みをお互い出し合って、良い製品を作り上げるように努力しています。
設立からまだ2年ですが、アジア各国へのECマーケティングを中心に着実に成長してきています。
実施スケジュール
2020.1月中旬 クラウドファンディング終了
2020.2月上旬から2月下旬まで 製造
2020.3月中旬から下旬 先にご支援いただいた方から順次発送
Q&A
Q.保証はありますか?
A.商品到着から2週間以内に壊れていることがわかった場合は無償で新品と交換させていただきます。また商品送料は当社が負担いたします。
Q.ダークブルー・メタルチタン以外の別の色が欲しいのですが。
A.今回の生産では間に合いませんが、今回ご希望の多い別の色がわかりましたが次回以降、製造する可能性があります。ご質問欄に入れていただけると嬉しいです。
Q.他のチタン製サーモボトルと何が違うんですか?
A.手前味噌になってしまいますが、私たちの商品はなんちゃって商品ではありません。今回の商品もチタン製造を得意とする上場企業と共に製造をしております。
また他社の製品と比べると軽くて大容量のサーモボトルかと思います。
Q.スポーツドリンクを入れることはできますか?
A.チタン製品は表面が腐食しないのでご利用いただけます。
質問を受け付けております。よろしくお願いします。
<All-in方式の場合>
本プロジェクトはAll-in方式で実施します。目標金額に満たない場合も、計画を実行し、リターンをお届けします。

最新の活動報告
もっと見る商品の発送が開始されました。
2020/04/16 21:43こちらの活動報告は支援者限定の公開です。現在通関待ちです
2020/03/03 11:05こちらの活動報告は支援者限定の公開です。
XXIIシリーズ3弾目、純チタン製スプーン&フォークのプロジェクト開始
2020/01/10 18:00第二弾サーモボトルをご支援頂いた皆様へ本日第三弾の純チタン製スプーンとフォークのセットを支援するプロジェクトを立ち上げました。こちらは他社スプーン、フォークと比べたくさんのチタンを使った物になります。またたくさんのチタンを利用したため重心が手元に寄り操作しやすい作りとなっております。ぜひこちらからご確認いただき、ご支援いただければ幸いです。https://camp-fire.jp/projects/view/224454サーモボトルも残り日数わずかとなりました。引き続きよろしくお願いしたします。 もっと見る











コメント
もっと見る